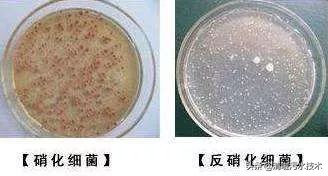
污水池降温措施,污水生化池怎么降温的

作者:小啦,污水运营,文字编辑、污水处理、学习与个人成长,关注并私信我回复数字“01”,送你一份新手污水入门大礼包。
气温降低常常会使污水厂面临严峻挑战,尤其是对活性污泥生长、脱氮除磷效果有较大影响。
在一定温度范围内,来水温度每降低10℃,微生物活性随之下降一倍,当水温低于4℃时,微生物几乎停止生命活动,污水处理效果下降甚至完全消失。
因此,为了平衡低温带来的不利影响,需要在水温尚未发生较大变化的时候提前控制好运行参数,以适应环境变化的需要。
低温对污水厂有哪些影响?
1 低温会减弱硝化、反硝化作用
硝化细菌的可生存环境温度在4-45℃之间,亚硝化菌的最适温度为35℃,硝酸菌的最适温度是35-42℃。
在最适温度以下随着温度降低硝化细菌的活性也随之下降,当温度下降10℃,硝化细菌最大比增殖速率和活性至少降低一半,12℃时反应速率下降50%,在5℃时停止硝化作用。
反硝化的最适温度在15-20℃之间,低于此温度时反硝化菌的代谢能力降低到较低水平,反硝化反应受到明显抑制,当温度低于5℃时反硝化作用几乎停止。
2 低温会间接影响生物除磷效果
聚磷菌为耐冷菌,通常正常运行时温度降低对其影响应该不大,但在实际运行过程中效果会有明显下降。
在低温环境下对生物除磷的影响主要有3个方面:温度降低影响微生物的新陈代谢和生理活性,微生物增殖速度下降,从而影响聚磷菌的释磷和吸磷的效果,导致系统的除磷功能下降 。

显微镜下的聚磷菌
低温情况下,聚糖菌成为了生化系统中的优势菌群,聚磷菌的优势地位遭到破坏。对于活性污泥和生物膜耦合的新型脱氮除磷工艺,在低温条件下,总磷的去除率受有机负荷的影响比正常温度更明显。
3 低温可能会引起污泥膨胀
当气温较低时,污水中正常的活性菌群生长受到抑制,繁殖缓慢。而其中适合低温生长的微丝菌属微生物在适宜温度下却会大量繁殖生长。
这些菌属会在生长过程中互相勾连、聚合成团,从而形成较大的颗粒,产生大量的剩余污泥,如不及时排除,就会引起污水处理厂的污泥膨胀。
4 低温降低了污泥沉降性能
气温降低后,活性污泥中微生物菌群的活性降低,其细胞表面胞外聚合物的分泌量减少,微生物之间的相互作用降低,难以结合形成团状聚合物。
这会导致活性污泥颗粒细碎,不易形成大颗粒絮状物,从而使得污泥颗粒的沉降性能下降,降低了泥水分离的效果,导致出水中常有细小悬浮颗粒出现,影响了出水效果。
5 低温降低了污泥活性
低温会严重影响微生物的代谢,导致污泥活性下降。主要体现在以下3个方面:
在低温情况下活性污泥中的微生物表面蛋白质的活性降低,其表面的原生质膜流动性下降,从而不利于微生物进行营养物质的运输。

显微镜下的活性污泥
较低的温度也抑制了微生物体内酶的活性,阻碍了微生物对营养物质的利用,使微生物不能正常进行营养吸收,从而抑制了微生物的生长,使活性污泥中微生物菌群数量下降,活性大为降低。
脱氮除磷过程中硝化菌、聚磷菌等微生物的活性也会受到温度的影响,生长速率降低,导致污泥龄增长,从而出现这些活性微生物流失的现象。
6 低温会影响微生物所需养料溶解度
低温通常会使有机物在水中的溶解度下降,然而不同有机物在水中的溶解度不同,其溶解度受到温度变化而变化的趋势也不尽相同。
较低的水温使得活性污泥中各种微生物生长所需的养料溶解度发生变化可能会使不同营养组分之间的比例发生变化,可能偏离了微生物生长所需的最佳比例,不利于微生物的代谢过程。

显微镜下的微生物
较低的水温整体降低了水中微生物生长所需的营养来源的含量,相比水温较高的情况下,可能需要投加更多的营养物质才能保证活性污泥中微生物的正常生长,增加了污水处理厂的运营成本;
大量本应作为能量来源的有机物不能溶解于水中被微生物利用,也可能会导致产生大量污泥,影响活性污泥的浓度。
低温情况下的工艺调整措施
1 尽早人为干预,提高微生物对低温适应性
一般来说,微生物会在生长代谢的过程中逐渐适应周围环境的温度,但这一适应过程通常需要耗费较长的时间。
目前多数城市季节过渡不明显,秋冬来临常常伴随环境温度都突然降低。这种情况下,微生物很难在短期内轻易适应,需要人为来补充更适应环境的微生物。
因此,污水厂应总结往年气温变化规律,据此提前做好相应预案,在秋季气温刚开始下降时,缓慢的进行 活性污泥的置换,稳步提高微生物对低温天气的适应性。
2 注重污水营养组分含量,调整有机组分比例
活性污泥中微生物的活性受环境温度影响极大,低温时微生物的正常生长会受到极大抑制。为了保持低温条件下微生物的生长增殖、新陈代谢,需要污水处理厂密切关注污水中各营养组分的含量,并根据实际情况适当调整有机组分的比例。

复合碳源
比如,污水处理厂可通过补充碳源或者调整碳源、氮源等营养组分比例。这样做可以为微生物的生长提供充足的养分和合适的营养,以保障微生物的正常生长,从而使活性污泥在秋冬季低温条件下,依然保持足够的活力,维持污水处理厂的有效运行。
3 保证污泥稳定排放,控制污泥泥龄
有经验的运维人员肯定知道,秋冬季节活性污泥中的微生物活性较低,因此大多会选择提高污泥浓度来保持活性。

排出后的污泥
但这种做法常常伴有一些风险。稳定运行的活性污泥内蕴含有大量微生物,如果短时间内通过不脱泥或者少脱泥来实现污泥浓度的提升,会使微生物生长时间过长,从而会引起污泥过度老化,最终导致产生生物泡沫或者污泥膨胀。
因此,无论是任何工况调整,都必须保证剩余污泥的稳定排放。污水处理厂应该在保证污泥稳定排放的前提下,采用一些较为缓和的措施来控制污泥泥龄,这需要一个较长时间的工艺调整过程。
我是小啦,点击上方“关注”,每天为你分享污水处理千货,私信我回复数字“01”,送你一份污水处理入门大礼包